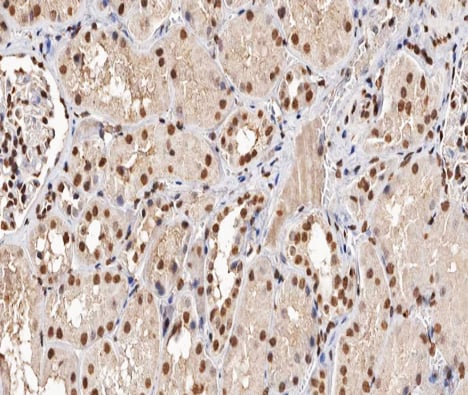
product-image-AAA321468_IHC13.jpg

Rabbit anti-Human p53 Polyclonal Antibody | anti-TP53 antibody
Phospho-p53 (Ser315) Antibody
Phosphate buffered saline, pH 7.4, 150mM NaCl, 0.02% sodium azide and 50% glycerol.
WB (Western Blot)
(Western blot analysis of p53 phosphorylation expression in ovary cancer whole cell lysates, The lane on the left is treated with the antigen-specific peptide.)
IHC (Immunohiostchemistry)
(AAA321468 at 1/200 staining human kidney sections by IHC-P. The tissue was formaldehyde fixed and a heat mediated antigen retrieval step in citrate buffer was performed. The tissue was then blocked and incubated with the antibody for 1.5 hours at 22 degree C. An HRP conjugated goat anti-rabbit antibody was used as the secondary.)
IF (Immunofluorescence)
(AAA321468 staining MDA-MB-435 by IF/ICC. The sample were fixed with PFA and permeabilized in 0.1% Triton X-100, then blocked in 10% serum for 45 minutes at 25 degree C. The primary antibody was diluted at 1/200 and incubated with the sample for 1 hour at 37 degree C. An Alexa Fluor 594 conjugated goat anti-rabbit IgG (H+L) Ab, diluted at 1/600, was used as the secondary antibody.)
Function: Acts as a tumor suppressor in many tumor types; induces growth arrest or apoptosis depending on the physiological circumstances and cell type. Involved in cell cycle regulation as a trans-activator that acts to negatively regulate cell division by controlling a set of genes required for this process. One of the activated genes is an inhibitor of cyclin-dependent kinases. Apoptosis induction seems to be mediated either by stimulation of BAX and FAS antigen expression, or by repression of Bcl-2 expression. In cooperation with mitochondrial PPIF is involved in activating oxidative stress-induced necrosis; the function is largely independent of transcription. Induces the transcription of long intergenic non-coding RNA p21 (lincRNA-p21) and lincRNA-Mkln1. LincRNA-p21 participates in TP53-dependent transcriptional repression leading to apoptosis and seem to have to effect on cell-cycle regulation. Implicated in Notch signaling cross-over. Prevents CDK7 kinase activity when associated to CAK complex in response to DNA damage, thus stopping cell cycle progression. Isoform 2 enhances the transactivation activity of isoform 1 from some but not all TP53-inducible promoters. Isoform 4 suppresses transactivation activity and impairs growth suppression mediated by isoform 1. Isoform 7 inhibits isoform 1-mediated apoptosis. Regulates the circadian clock by repressing CLOCK-ARNTL/BMAL1-mediated transcriptional activation of PER2 (PubMed:24051492).
Subunit Structure: Interacts with AXIN1. Probably part of a complex consisting of TP53, HIPK2 and AXIN1 (By similarity). Binds DNA as a homotetramer. Interacts with histone acetyltransferases EP300 and methyltransferases HRMT1L2 and CARM1, and recruits them to promoters. In vitro, the interaction of TP53 with cancer-associated/HPV (E6) viral proteins leads to ubiquitination and degradation of TP53 giving a possible model for cell growth regulation. This complex formation requires an additional factor, E6-AP, which stably associates with TP53 in the presence of E6. Interacts (via C-terminus) with TAF1; when TAF1 is part of the TFIID complex. Interacts with ING4; this interaction may be indirect. Found in a complex with CABLES1 and TP73. Interacts with HIPK1, HIPK2, and TP53INP1. Interacts with WWOX. May interact with HCV core protein. Interacts with USP7 and SYVN1. Interacts with HSP90AB1. Interacts with CHD8; leading to recruit histone H1 and prevent transactivation activity (By similarity). Interacts with ARMC10, BANP, CDKN2AIP, NUAK1, STK11/LKB1, UHRF2 and E4F1. Interacts with YWHAZ; the interaction enhances TP53 transcriptional activity. Phosphorylation of YWHAZ on 'Ser-58' inhibits this interaction. Interacts (via DNA-binding domain) with MAML1 (via N-terminus). Interacts with MKRN1. Interacts with PML (via C-terminus). Interacts with MDM2; leading to ubiquitination and proteasomal degradation of TP53. Directly interacts with FBXO42; leading to ubiquitination and degradation of TP53. Interacts (phosphorylated at Ser-15 by ATM) with the phosphatase PP2A-PPP2R5C holoenzyme; regulates stress-induced TP53-dependent inhibition of cell proliferation. Interacts with PPP2R2A. Interacts with AURKA, DAXX, BRD7 and TRIM24. Interacts (when monomethylated at Lys-382) with L3MBTL1. Isoform 1 interacts with isoform 2 and with isoform 4. Interacts with GRK5. Binds to the CAK complex (CDK7, cyclin H and MAT1) in response to DNA damage. Interacts with CDK5 in neurons. Interacts with AURKB, SETD2, UHRF2 and NOC2L. Interacts (via N-terminus) with PTK2/FAK1; this promotes ubiquitination by MDM2. Interacts with PTK2B/PYK2; this promotes ubiquitination by MDM2. Interacts with PRKCG. Interacts with PPIF; the association implicates preferentially tetrameric TP53, is induced by oxidative stress and is impaired by cyclosporin A (CsA). Interacts with human cytomegalovirus/HHV-5 protein UL123. Interacts with SNAI1; the interaction induces SNAI1 degradation via MDM2-mediated ubiquitination and inhibits SNAI1-induced cell invasion. Interacts with KAT6A. Interacts with UBC9. Interacts with ZNF385B; the interaction is direct. Interacts (via DNA-binding domain) with ZNF385A; the interaction is direct and enhances p53/TP53 transactivation functions on cell-cycle arrest target genes, resulting in growth arrest. Interacts with ANKRD2. Interacts with RFFL and RNF34; involved in p53/TP53 ubiquitination. Interacts with MTA1 and COP1. Interacts with CCAR2 (via N-terminus). Interacts (via N-terminus) with human adenovirus 5 E1B-55K protein; this interaction leads to the inhibition of TP53 function and/or its degradation (PubMed:25772236). Interacts with MORC3 (PubMed:17332504). Interacts (via C-terminus) with POU4F2 isoform 1 (via C-terminus) (PubMed:17145718). Interacts (via oligomerization region) with NOP53; the interaction is direct and may prevent the MDM2-mediated proteasomal degradation of TP53 (PubMed:22522597). Interacts with AFG1L; mediates mitochondrial translocation of TP53 (PubMed:27323408). Interacts with UBD (PubMed:25422469).
Post-translational Modifications: Acetylated. Acetylation of Lys-382 by CREBBP enhances transcriptional activity. Deacetylation of Lys-382 by SIRT1 impairs its ability to induce proapoptotic program and modulate cell senescence. Deacetylation by SIRT2 impairs its ability to induce transcription activation in a AKT-dependent manner. Phosphorylation on Ser residues mediates transcriptional activation. Phosphorylated by HIPK1 (By similarity). Phosphorylation at Ser-9 by HIPK4 increases repression activity on BIRC5 promoter. Phosphorylated on Thr-18 by VRK1. Phosphorylated on Ser-20 by CHEK2 in response to DNA damage, which prevents ubiquitination by MDM2. Phosphorylated on Ser-20 by PLK3 in response to reactive oxygen species (ROS), promoting p53/TP53-mediated apoptosis. Phosphorylated on Thr-55 by TAF1, which promotes MDM2-mediated degradation. Phosphorylated on Ser-33 by CDK7 in a CAK complex in response to DNA damage. Phosphorylated on Ser-46 by HIPK2 upon UV irradiation. Phosphorylation on Ser-46 is required for acetylation by CREBBP. Phosphorylated on Ser-392 following UV but not gamma irradiation. Phosphorylated on Ser-15 upon ultraviolet irradiation; which is enhanced by interaction with BANP. Phosphorylated by NUAK1 at Ser-15 and Ser-392; was initially thought to be mediated by STK11/LKB1 but it was later shown that it is indirect and that STK11/LKB1-dependent phosphorylation is probably mediated by downstream NUAK1 (PubMed:21317932). It is unclear whether AMP directly mediates phosphorylation at Ser-15. Phosphorylated on Thr-18 by isoform 1 and isoform 2 of VRK2. Phosphorylation on Thr-18 by isoform 2 of VRK2 results in a reduction in ubiquitination by MDM2 and an increase in acetylation by EP300. Stabilized by CDK5-mediated phosphorylation in response to genotoxic and oxidative stresses at Ser-15, Ser-33 and Ser-46, leading to accumulation of p53/TP53, particularly in the nucleus, thus inducing the transactivation of p53/TP53 target genes. Phosphorylated by DYRK2 at Ser-46 in response to genotoxic stress. Phosphorylated at Ser-315 and Ser-392 by CDK2 in response to DNA-damage. Dephosphorylated by PP2A-PPP2R5C holoenzyme at Thr-55. SV40 small T antigen inhibits the dephosphorylation by the AC form of PP2A. May be O-glycosylated in the C-terminal basic region. Studied in EB-1 cell line. Ubiquitinated by MDM2 and SYVN1, which leads to proteasomal degradation (PubMed:10722742, PubMed:12810724, PubMed:15340061, PubMed:17170702, PubMed:19880522). Ubiquitinated by RFWD3, which works in cooperation with MDM2 and may catalyze the formation of short polyubiquitin chains on p53/TP53 that are not targeted to the proteasome (PubMed:10722742, PubMed:12810724, PubMed:20173098). Ubiquitinated by MKRN1 at Lys-291 and Lys-292, which leads to proteasomal degradation (PubMed:19536131). Deubiquitinated by USP10, leading to its stabilization (PubMed:20096447). Ubiquitinated by TRIM24, RFFL, RNF34 and RNF125, which leads to proteasomal degradation (PubMed:19556538). Ubiquitination by TOPORS induces degradation (PubMed:19473992). Deubiquitination by USP7, leading to stabilization (PubMed:15053880). Isoform 4 is monoubiquitinated in an MDM2-independent manner (PubMed:15340061). Ubiquitinated by COP1, which leads to proteasomal degradation (PubMed:19837670). Ubiquitination and subsequent proteasomal degradation is negatively regulated by CCAR2 (PubMed:25732823). Monomethylated at Lys-372 by SETD7, leading to stabilization and increased transcriptional activation. Monomethylated at Lys-370 by SMYD2, leading to decreased DNA-binding activity and subsequent transcriptional regulation activity. Lys-372 monomethylation prevents interaction with SMYD2 and subsequent monomethylation at Lys-370. Dimethylated at Lys-373 by EHMT1 and EHMT2. Monomethylated at Lys-382 by KMT5A, promoting interaction with L3MBTL1 and leading to repress transcriptional activity. Dimethylation at Lys-370 and Lys-382 diminishes p53 ubiquitination, through stabilizing association with the methyl reader PHF20. Demethylation of dimethylated Lys-370 by KDM1A prevents interaction with TP53BP1 and represses TP53-mediated transcriptional activation. Sumoylated with SUMO1. Sumoylated at Lys-386 by UBC9.
Similarity: The nuclear export signal acts as a transcriptional repression domain. The TADI and TADII motifs (residues 17 to 25 and 48 to 56) correspond both to 9aaTAD motifs which are transactivation domains present in a large number of yeast and animal transcription factors. Belongs to the p53 family.
NCBI and Uniprot Product Information
Predicted: 44 kDa
Customer Reviews
Loading reviews...
Share Your Experience
Similar Products
Product Notes
The TP53 tp53 (Catalog #AAA321468) is an Antibody produced from Rabbit and is intended for research purposes only. The product is available for immediate purchase. The Phospho-p53 (Ser315) Antibody reacts with Human and may cross-react with other species as described in the data sheet. AAA Biotech's p53 can be used in a range of immunoassay formats including, but not limited to, ELISA, IP (Immunoprecipitation), ICC (Immunocytochemistry), IF (Immunofluorescence), IHC (Immunohistochemistry), WB (Western Blot). Researchers should empirically determine the suitability of the TP53 tp53 for an application not listed in the data sheet. Researchers commonly develop new applications and it is an integral, important part of the investigative research process. It is sometimes possible for the material contained within the vial of "p53, Polyclonal Antibody" to become dispersed throughout the inside of the vial, particularly around the seal of said vial, during shipment and storage. We always suggest centrifuging these vials to consolidate all of the liquid away from the lid and to the bottom of the vial prior to opening. Please be advised that certain products may require dry ice for shipping and that, if this is the case, an additional dry ice fee may also be required.Precautions
All products in the AAA Biotech catalog are strictly for research-use only, and are absolutely not suitable for use in any sort of medical, therapeutic, prophylactic, in-vivo, or diagnostic capacity. By purchasing a product from AAA Biotech, you are explicitly certifying that said products will be properly tested and used in line with industry standard. AAA Biotech and its authorized distribution partners reserve the right to refuse to fulfill any order if we have any indication that a purchaser may be intending to use a product outside of our accepted criteria.Disclaimer
Though we do strive to guarantee the information represented in this datasheet, AAA Biotech cannot be held responsible for any oversights or imprecisions. AAA Biotech reserves the right to adjust any aspect of this datasheet at any time and without notice. It is the responsibility of the customer to inform AAA Biotech of any product performance issues observed or experienced within 30 days of receipt of said product. To see additional details on this or any of our other policies, please see our Terms & Conditions page.Item has been added to Shopping Cart
If you are ready to order, navigate to Shopping Cart and get ready to checkout.